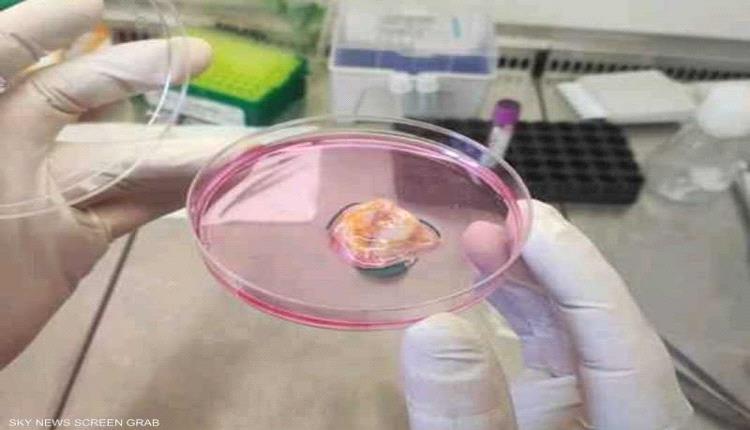
مركز أبوظبي للخلايا الجذعية يطلق علاجا مبتكرا للسرطان

ويأتي هذا الإعلان بالتزامن مع احتفالات دولة الإمارات باليوم الوطني، ليجسد روح الابتكار والتطور التي تميّز مسيرة الدولة. كما يؤكد هذا الإنجاز التزام مركز أبوظبي للخلايا الجذعية بتوفير أحدث العلاجات الطبية عالمياً داخل الدولة، دون الحاجة إلى سفر المرضى للخارج، وتعزيز مكانة الإمارات كمركز رائد للابتكار الطبي.
ويتميز المركز بمختبراته المتوافقة مع معايير ممارسات التصنيع الجيد (GMP)، إضافة إلى بروتوكولات السلامة الصارمة التي تضمن إنتاج العلاج وفق أعلى المعايير العالمية.
ويؤسس هذا الإنجاز لمرحلة جديدة تشمل إنتاج الخلايا اللمفاوية المتسللة إلى الأورام وخلايا TCR المعدلة وراثياً على نطاق صناعي، تمهيدا لإطلاق تجارب سريرية مستقبلية.
وفي هذا الصدد قال البروفيسور يندري فينتورا، الرئيس التنفيذي لمركز أبوظبي للخلايا الجذعية: "هذا ليس مجرد علاج جديد، بل هو نموذج جديد كلياً في رعاية مرضى السرطان في الإمارات والمنطقة. فمن خلال تطوير هذا العلاج محليا، نوفر لمرضانا خيارا علاجيا متقدما، ونساهم في إثراء المعرفة العلمية عالميا. كما يمثل هذا البرنامج خطوة فخر واعتزاز لوطننا، كما ينسجم تماماً مع الرؤية الريادية التي نقترب من الاحتفال بها في اليوم الوطني لدولة الامارات."
ويعتزم مركز أبوظبي للخلايا الجذعية خلال المرحلة المقبلة إطلاق دراسات سريرية لجمع عينات الأورام الأولية، تمهيداً لتوسيع نطاق العلاج وإتاحته للمرضى المؤهلين في دولة الإمارات من خلال التجارب السريرية المستقبلية.
![]() تابعوا آخر أخبارنا المحلية وآخر المستجدات السياسية والإقتصادية عبر Google news
تابعوا آخر أخبارنا المحلية وآخر المستجدات السياسية والإقتصادية عبر Google news